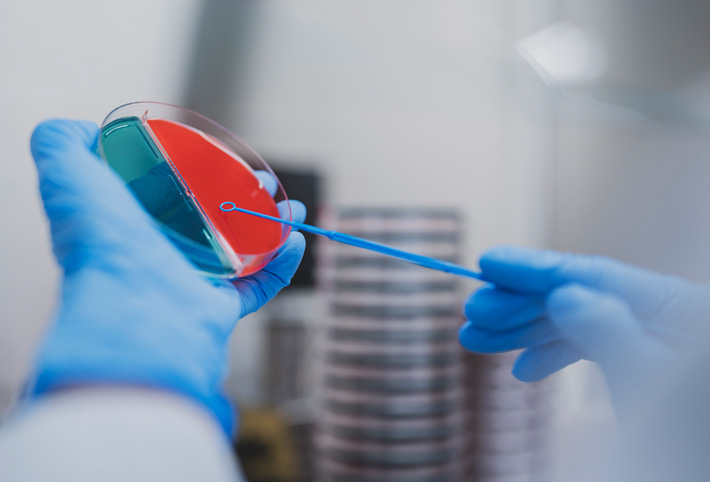

検査項目
inspection items臨床検査について
臨床検査は、患者さまから採取した血液や尿、便、細胞などを調べる「検体検査」と、心電図や脳波など、患者さまを直接調べる「生理機能検査」の2つに大きく分けられます。
検体検査は、患者さまから検体を採取するところまでは医療行為とみなされるため、医療機関でしか行えませんが、採取後の検体については、適切な保存条件(温度や時間)が守られれば医療機関外での検査が可能です。そのようなことから、多くの医療機関では検体検査の一部またはすべてを、我々衛生検査所に委託しています。
(更新日)2025年7月
更新日以降の内容変更は、別にお持ちする「検査内容変更のお知らせ」等をご参照ください

分野別で見た検査の概要
| 血液学的検査 | 赤血球や白血球の数や分類を検査することにより、貧血や炎症の程度、血液疾患がわかります。 |
|---|---|
| 凝固学的検査 | 血液の固まりやすさを検査することにより、出血性疾患や血栓症、肝機能の状態がわかります。抗凝固薬のモニタリングも行うことができます。 |
| 生化学的検査 | 血液中の蛋白や酵素、糖質、脂質、電解質など様々な成分を分析することにより、全身の総合的な状態を把握できます。 |
| 免疫血清学的検査 | 血液中の抗原や抗体を検査することにより、感染症の診断、アレルギー、自己免疫疾患などがわかります。 |
| 腫瘍関連検査 | がんで特異的に生産される蛋白である腫瘍マーカーを検出することにより、がん診断の補助となります。また、治療効果の判定にも役立ちます。 |
| 内分泌学的検査 | 体内に分泌される微量のホルモンを検査することにより内分泌疾患の病態を把握できます。 |
| 微生物学的検査 | 喀痰や尿、便などに存在する微生物を検出することにより、感染症の診断に役立てます。また、感受性試験の結果から最適な抗菌薬を選択することができます。 |
| 輸血・移植検査 | 血液型検査や不規則抗体検査、交差適合試験を行うことにより、安全な輸血医療を行うことができます。 |
| 尿・糞便等一般検査 | 尿中に含まれる成分を検査することにより、腎臓や肝臓、泌尿器系の疾患がわかります。 また、便中の血液を検出することにより、消化器疾患の診断補助に役立てます。 |
| 病理組織・細胞診検査 | 組織や細胞を顕微鏡レベルで観察することにより、がんや様々な疾患の診断が可能です。 また、診断のみならず、治療方針や治療効果の判定にも役立ちます。 |
| 病原体遺伝子検査 | 病原の遺伝子(DNA、RNA)を検出することにより、感染症の診断が可能です。 |
